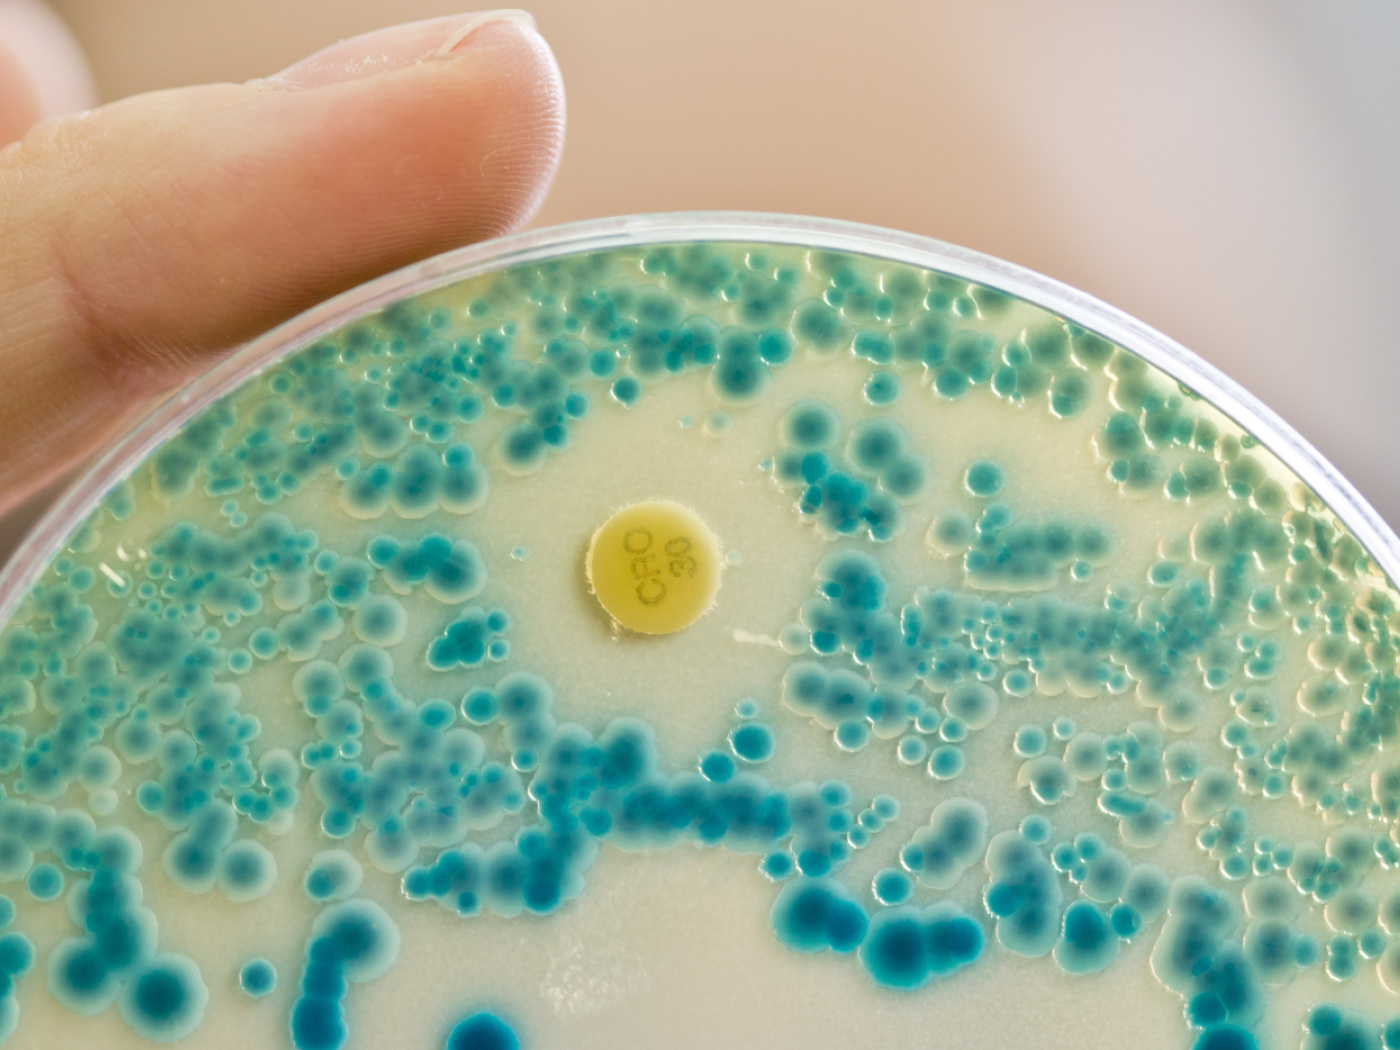

AI can help detect antibiotic-resistant bacteria
Researchers at the University of Zurich (UZH) have used artificial intelligence to detect antibiotic-resistant microbes for the first time. The AI model GPT-4 from OpenAI was used to interpret the laboratory tests.
Based on this AI programme, the researchers created a system that was tested on hundreds of bacteria and helped to identify resistance to vital antibiotics, as reported by UZH. Although the AI system achieved good results, it was not perfect.

More
Big Pharma steps up race for AI-discovered drugs
According to the researchers, human experts were more accurate. However, the AI system could help to standardise and speed up the diagnostic process.
“Our research is the first step towards using AI in routine diagnostics so that doctors can identify resistant bacteria more quickly,” said study leader Adrian Egli from the Institute of Medical Microbiology in a press release.
The study shows the potential of AI in the healthcare sector. The system could ultimately help to reduce the variability and subjectivity of manual evaluations and thus improve the results for patients.
Adapted from German by DeepL/ac
This news story has been written and carefully fact-checked by an external editorial team. At SWI swissinfo.ch we select the most relevant news for an international audience and use automatic translation tools such as DeepL to translate it into English. Providing you with automatically translated news gives us the time to write more in-depth articles.
If you want to know more about how we work, have a look here, if you want to learn more about how we use technology, click here, and if you have feedback on this news story please write to english@swissinfo.ch.

In compliance with the JTI standards
More: SWI swissinfo.ch certified by the Journalism Trust Initiative



























You can find an overview of ongoing debates with our journalists here . Please join us!
If you want to start a conversation about a topic raised in this article or want to report factual errors, email us at english@swissinfo.ch.